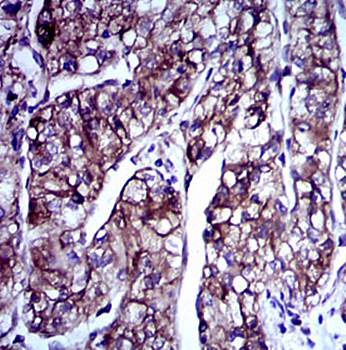
DCX Antibody

You have no items in your shopping cart.
All Products
- Featured

- Featured

- Featured

- Featured

- Featured
 DCX Antibody [orb97486]Featured
DCX Antibody [orb97486]Featured
FC, ICC, IHC, WB
Human, Monkey, Mouse, Rabbit, Rat
Mouse
Monoclonal
Unconjugated
100 μl - Featured

- Featured

- Featured

- Featured
 CCL2 Antibody [orb97456]Featured
CCL2 Antibody [orb97456]Featured
FC, ICC, IHC, WB
Human, Monkey, Mouse, Rat
Mouse
Monoclonal
Unconjugated
100 μl